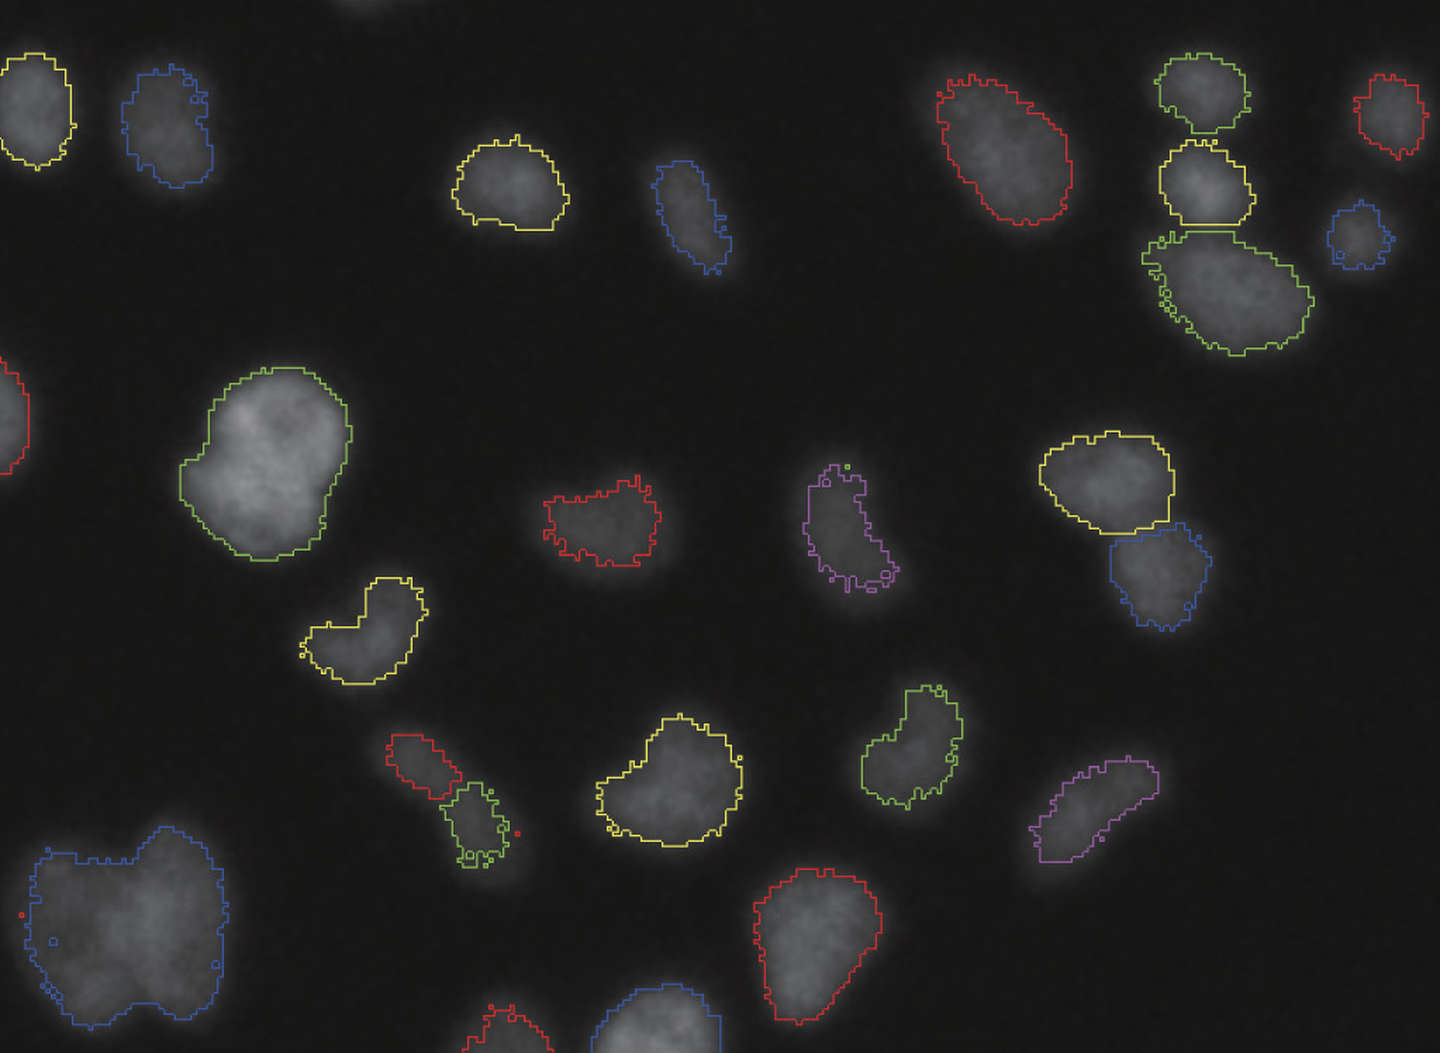
undefined

Digital Sight 50M
产品简述:显微镜用单色数码相机Digital Sight 50M为了提高工作流程的效率而进行了优化。除了高水平的像素数、视野数、速度以外,还搭载专用套装软件。在大量样品筛选中也很有效。这款数码相机不仅适用于学术研究,还适用于创药研究。
025-83194005
电话咨询

产品简述:显微镜用单色数码相机Digital Sight 50M为了提高工作流程的效率而进行了优化。除了高水平的像素数、视野数、速度以外,还搭载专用套装软件。在大量样品筛选中也很有效。这款数码相机不仅适用于学术研究,还适用于创药研究。
025-83194005
电话咨询
主要特性
显著改善大量样品捕获和分析的工作流程
单孔单次自动对焦的大视场和高分辨率
单次自动对焦可捕捉7mm(使用2X物镜时)的宽视野。可在短时间内快速确认孔板之类的标本数多的样品全貌和样品的感兴趣区域,因此还可提高实验再现性。


9K的超高分辨率增加定量分析的可靠性
像素数进化到原来的3.8倍,分辨率进化到2.5倍。即使使用低倍率/高NA的物镜时,也可最大限度地发挥物镜的光学性能。图像分析时也可以捕捉具有高可靠性的局部区域的数据。
Digital Sight 50M

Conventional
还配备适用于大量筛选的软件

与软件“NIS-Elements HC”组合,还可支持捕捉后的分析。它可以建立一个从选孔、自动检测图像ROI并显示分析结果的流程。
孔板视图
热图
样品标签
二值图像
图表显示(直方图、散点图、柱状图等)

自动检测细胞密度和分布均匀的区域并以高倍率捕捉

自动检测满足事先指定条件的区域并以高倍率捕捉
高灵敏度

微弱的荧光信号也可捕捉
实现了85%的量子效率。凭借3.76 μm的宽像素间距和高量子效率,可将微弱的荧光信号也捕捉到每个像素中
低噪音


以超低噪音获取微弱的荧光信号
通过高满阱容量与1.0e- /p/s暗电流组合实现的6e-读出噪音,能够以非常低的噪音获取14bit的荧光图像。
根据用途备有

2.5X/1.8X/1X等三种相机适配器
Digital Sight 50M搭载了大尺寸的CIS(Nikon FX format),可实现FOV25的大视场观察。
适配器可根据用途区别使用,2.5X/1.8X适配器适用于使用60M像素高分辨率的单次自动对焦捕捉;1X适配器适用于图像拼接等要求高灵敏度/低噪音的样品。
延时摄影
与 NIS-Elements 软件组合实现荧光延时成像
具有大视场、高像素密度以及低噪音的Digital Sight 50M是时间分辨成像应用的理想选择。
丰富的图像尺寸模式

画质与速度之间的可调节平衡
备有多Binning模式。可选择所需的速度和画质。最大可实现225.9fps的高速捕捉
*本公司产品中任何描述性词语不具备对其他品牌产品的排他性,仅限于对比本品牌前期产品。
如有疑异,可通过025-83194005联系。*
| Digital Sight 50M | |
|---|---|
| 图像传感器 | Nikon FX-格式单色 CMOS 图像传感器 尺寸:35.8×23.8mm |
| 可刻录像素 | 全像素:9552×6336 |
| 镜头卡口 | F卡口 |
| 制冷方式 | 电子制冷 |
| ISO感光度(推荐曝光指数) | 相当于ISO200 |
| 量子效率 | 85% |
| 满阱容量 | 45000e- (typ.) |
| 读出噪音 | 6e– |
| 暗电流 | 1.0e-/p/s(Ta=25 °C)(typ.) |
| 实时显示模式* | 全像素 (9552×6336):6fps 3x3像素平均值@8bit(ROI 640×480):225.9fps** |
| 曝光时间 | 150微秒–120秒 |
| 光度测定模式 | 平均光度测量:测光区域内的平均强度峰值光度测量:测光区域内的最大强度 |
| 曝光控制 | 一次性自动曝光:曝光时间会在相机的最佳范围内自动调整一次 连续自动曝光:连续执行自动曝光调节以保持相机内的曝光 手动曝光:曝光时间和增益设置是手动完成的 |
| 曝光校正 | 平均计量:±1EV步长:1/2EV峰值保持测量:-1EV至±0EV |
| 接口 | USB 3.2GEN1(连接PC)×1, 外部触发×1 |
| 电源 | AC100 ~240 V 50 Hz/60 Hz |
| 能量消耗 | 27 W |
| 操作环境 | 0-40°C, 最大 60% RH(无冷凝) |
* 最大帧速率取决于曝光时间。
** 当使用NIS-Elements时, 16位模式可用于1x1和2x2数字拼接,12位模式可用于2x2、3x3、4x4和 6x6。在所有图像尺寸模式中均可选用8位模式。
显微镜用单色数码相机Digital Sight 50M为了提高工作流程的效率而进行了优化。
除了高水平的像素数、视野数、速度以外,还搭载专用套装软件。在大量样品筛选中也很有效。这款数码相机不仅适用于学术研究,还适用于创药研究。
